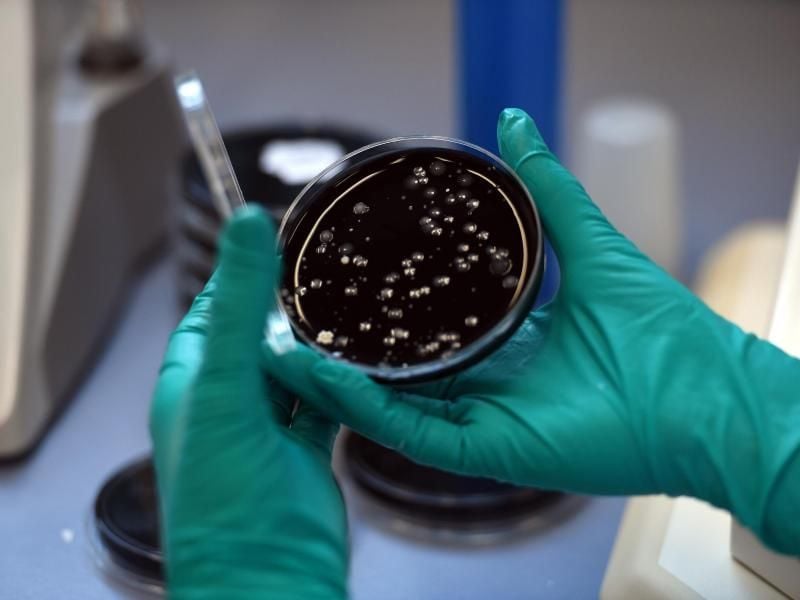
Nach der wochenlangen Schließung von Hotels, Sportanlagen und Schwimmbädern könnten die Trinkwasseranlagen vermehrt mit Legionellen belastet sein. Foto: picture alliance / dpa

RKI warnt vor Legionellen-Risiko in Wasseranlagen
Berlin - Das Robert Koch-Institut (RKI) warnt nach der wochenlangen Schließung von Hotels, Sportanlagen und Schwimmbädern vor einem möglichen Legionellen-Risiko. Bei unsachgemäßer oder fehlender Wartung könne es nach der Corona-Pause zu einem erhöhten Wachstum dieser Bakterien in Trinkwasseranlagen gekommen sein, schreibt das RKI im „Epidemiologischen Bulletin”.
Legionellen können bei Menschen Krankheiten auslösen - von grippeartigen Beschwerden bis hin zu schweren Lungenentzündungen. Die Erreger werden häufig durch zerstäubtes Wasser übertragen, etwa in Duschen, Whirlpools, durch Luftbefeuchter oder über Wasserhähne. Betreiber sollten vor einer Wiedereröffnung ihrer Trinkwasseranlagen deshalb einen einwandfreien Betrieb sicherstellen, rät das RKI.
Auch Ärzte sollten darauf achten, dass bei Atemwegsproblemen zurzeit eine Legionelleninfektion vorliegen könne. Dafür gibt es Test-Möglichkeiten.
Ideale Wachstumsbedingungen finden Legionellen bei Temperaturen zwischen 25 und 45 Grad Celsius. Bei Wassertemperaturen über 55 Grad wird das Wachstum der Keime nach RKI-Angaben gehemmt. Bei mehr als 60 Grad komme es zum Absterben der Keime.
Besonders anfällig für Legionellen sind Menschen mit einem geschwächten Immunsystem und mit bestimmten Grunderkrankungen wie zum Beispiel Diabetes sowie Herz- und Lungenleiden. Auch Raucher und ältere Menschen gelten an gefährdeter. Männer erkranken zwei- bis dreimal so häufig wie Frauen. Bei etwa fünf bis zehn Prozent der Patienten verläuft die Erkrankung tödlich. (dpa)



